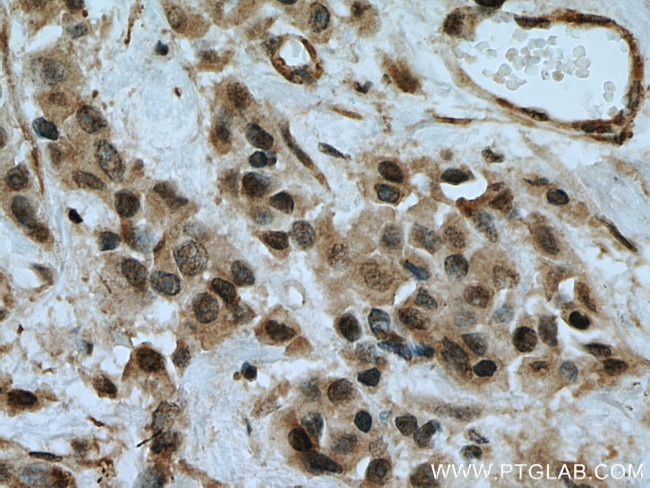
MEK6 Antibody in Immunohistochemistry (Paraffin) (IHC (P))

Search
Proteintech
MEK6 Polyclonal Antibody
{{$productOrderCtrl.translations['antibody.pdp.commerceCard.promotion.promotions']}}
{{$productOrderCtrl.translations['antibody.pdp.commerceCard.promotion.viewpromo']}}
{{$productOrderCtrl.translations['antibody.pdp.commerceCard.promotion.promocode']}}: {{promo.promoCode}} {{promo.promoTitle}} {{promo.promoDescription}}. {{$productOrderCtrl.translations['antibody.pdp.commerceCard.promotion.learnmore']}}
产品信息
12745-1-AP
种属反应
宿主/亚型
分类
类型
抗原
偶联物
形式
浓度
规格
纯化类型
保存液
内含物
保存条件
运输条件
产品详细信息
Immunogen sequence: MSQSKGKKR NPGLKIPKEA FEQPQTSSTP PRDLDSKACI SIGNQNFEVK ADDLEPIMEL GRGAYGVVEK MRHVPSGQIM AVKRIRATVN SQEQKRLLMD LDISMRTVDC PFTVTFYGAL FREGDVWICM ELMDTSLDKF YKQVIDKGQT IPEDILGKIA VSIVKALEHL HSKLSVIHRD VKPSNVLINA LGQVKMCDFG ISGYLVDSVA KTIDAGCKPY MAPERINPEL NQKGYSVKSD IWSLGITMIE LAILRFPYDS WGTPFQQLKQ VVEEPSPQLP ADKFSAEFVD FTSQCLKKNS KERPTYPELM QHPFFTLHES KGTDVASFVK LILGD (1-334 aa encoded by BC012009)
靶标信息
MKK6 (MEK6, MAP2K6) is a member of the dual specificity protein kinase family, which functions as a mitogen-activated protein (MAP) kinase kinase. MAP kinases, also known as extracellular signal-regulated kinases (ERKs), act as an integration point for multiple biochemical signals. This protein phosphorylates and activates p38 MAP kinase in response to inflammatory cytokines or environmental stress. As an essential component of p38 MAP kinase mediated signal transduction pathway, this gene is involved in many cellular processes such as stress induced cell cycle arrest, transcription activation and apoptosis. Tissue specificity: Isoform 2 is only expressed in skeletal muscle. Isoform 1, on the other hand, is found in skeletal muscle, heart, and in lesser extent in liver or pancreas.
仅用于科研。不用于诊断过程。未经明确授权不得转售。
生物信息学
蛋白别名: Colorectal Cancer Metastasis-Suppressed LncRNA; Dual specificity mitogen-activated protein kinase kinase 6; MAP kinase kinase 6; MAPK/ERK kinase 3; MAPK/ERK kinase 6; MAPKK 3; MAPKK 6; MAPKK3; MEK 3; MEK 6; MEK3; mitogen activated protein kinase kinase 6; MKK3; PRKMK3; protein kinase, mitogen activated, kinase 6; protein kinase, mitogen-activated, kinase 6 (MAP kinase kinase 6); SAPK kinase 2; SAPK kinase 3; SAPKK-2; SAPKK2; SAPKK3; Stress-activated protein kinase kinase 3; unnamed protein product
基因别名: CRCMSL; MAP2K6; MAPKK6; MEK6; MKK6; PRKMK6; SAPKK-3; SAPKK3; SKK3
UniProt ID: (Human) P52564, (Mouse) P70236
Entrez Gene ID: (Human) 5608, (Mouse) 26399